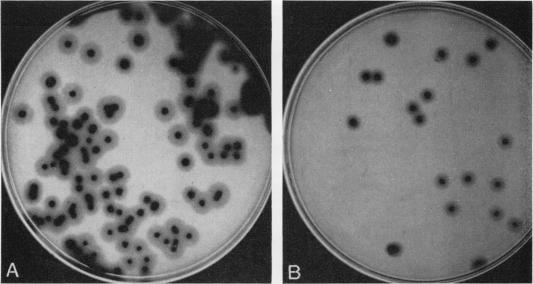

用于快速分析产气荚膜梭菌食品的新型定量、定性和确证培养基。
New quantitative, qualitative, and confirmatory media for rapid analysis of food for Clostridium perfringens.
作者信息
Shahidi S A, Ferguson A R
出版信息
Appl Microbiol. 1971 Mar;21(3):500-6. doi: 10.1128/am.21.3.500-506.1971.
A selective and differential medium, Shahidi-Ferguson Perfringens agar (SFP agar), and a confirmatory medium, lactose-motility agar (LM agar), were developed for the enumeration and identification of Clostridium perfringens in foods. These media provide a rapid, specific, and direct diagnosis of C. perfringens. SFP agar contains sodium metabisulfite and ferric ammonium citrate to demonstrate H(2)S production and egg yolk to demonstrate lecithinase production by C. perfringens. On SFP agar, C. perfringens produces black colonies, 2 to 3 mm in diameter, surrounded by zones of opaque precipitate. The typical colonies are confirmed on LM agar. Enumeration and identification are completed within 48 hr. All of the ingredients of SFP agar are stable to heat and storage conditions. SFP agar also contains two antibiotics, kanamycin and polymyxin B, which are inhibitory to many bacteria commonly occurring in foods. A comparative study of SFP agar and noninhibitory media showed that SFP agar did not inhibit any of the 16 strains of C. perfringens tested. Recovery of C. perfringens added to foods averaged 90.6% for SFP agar as compared with 69.8% for sulfite polymyxin-sulfadiazine (SPS) agar (BBL) and 60.2% for SPS agar (Difco). The colonies on the SFP agar, were much larger and were consistently black. Of 464 food samples tested, C. perfringens was found in 27 samples with SFP agar and in 5 samples with SPS agar (Difco), with a recovery ratio considerably higher on SFP agar. SFP agar is a more specific presumptive medium for the enumeration of C. perfringens and in conjunction with LM agar should save considerable time, effort, and materials toward the final identification of the species.
一种选择性鉴别培养基——沙希迪-弗格森产气荚膜梭菌琼脂(SFP琼脂)和一种确证培养基——乳糖动力琼脂(LM琼脂),被开发用于食品中产气荚膜梭菌的计数和鉴定。这些培养基可对产气荚膜梭菌进行快速、特异且直接的诊断。SFP琼脂含有焦亚硫酸钠和柠檬酸铁铵以检测硫化氢的产生,还含有蛋黄以检测产气荚膜梭菌卵磷脂酶的产生。在SFP琼脂上,产气荚膜梭菌产生直径为2至3毫米的黑色菌落,菌落周围有不透明沉淀带。典型菌落在LM琼脂上得到确证。计数和鉴定在48小时内完成。SFP琼脂的所有成分对热和储存条件都很稳定。SFP琼脂还含有两种抗生素——卡那霉素和多粘菌素B,它们对食品中常见的许多细菌具有抑制作用。对SFP琼脂和非抑制性培养基的比较研究表明,SFP琼脂对所测试的16株产气荚膜梭菌均无抑制作用。添加到食品中的产气荚膜梭菌,SFP琼脂的回收率平均为90.6%,相比之下,亚硫酸盐多粘菌素磺胺嘧啶(SPS)琼脂(BBL)为69.8%,SPS琼脂(Difco)为60.2%。SFP琼脂上的菌落大得多且始终为黑色。在所测试的464份食品样本中,用SFP琼脂检测到27份样本中产气荚膜梭菌,用SPS琼脂(Difco)检测到5份样本中有该菌,SFP琼脂的回收率要高得多。SFP琼脂是一种更特异的用于产气荚膜梭菌计数的推测性培养基,与LM琼脂结合使用,在最终鉴定该菌种时应可节省大量时间、精力和材料。